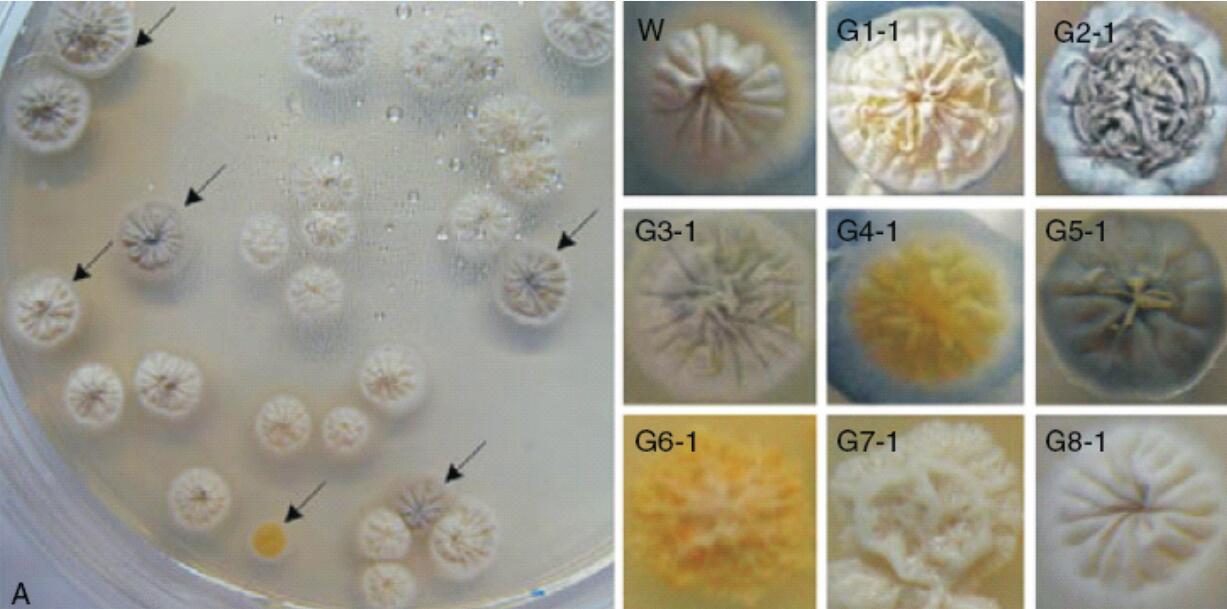
m-1

阿维菌素是阿维链霉菌发酵产生的具有抗虫活性的物质,高效低毒,在医药、农业和畜牧业生产上具有很高的应用价值。我国阿维菌素的生产菌株目前存在着发酵单位低、生产成本高等问题,采用新型诱变技术选育阿维菌素高产菌株成为关键。
ARTP处 理3min时,阿 维 链 霉 菌 的 致 死 率 高 达98.2%,突变率、正突变率分别为30%、21%,阿维菌素产量提高23%。
等离子体诱变前后阿维链霉菌的形态变化
(注:W为野生菌株;G1-8为典型突变菌株)
苏氨酸是一种重要的必需氨基酸,广泛应用于医疗、食品和饲料等行业,生产方法主要有蛋白质水解法、化学合成法和生物发酵法。通过诱变提高菌株性能,再进行生物发酵,已成为苏氨酸生产的首选方法。
ARTP处理1.5min时,获得一株苏氨酸高产菌株,摇 瓶 产 酸 达 到50.6 g/L, 与 出 发 菌 相 比 , 提 高 了99.6%,经50次传代,遗传性稳定。

出发菌株与1905#突变菌的菌体形态





